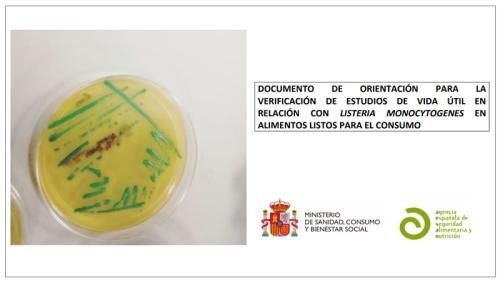
listeria

La Agencia Española de Seguridad Alimentaria y Nutrición (AESAN) y el Foro Interalimentario organizan la jornada "Seguridad Alimentaria en España". Su objetivo es reflexionar sobre el sistema de seguridad alimentaria en España, qué ocurre cuando surgen incidentes con repercusión en la salud pública, y la importancia de cambiar el concepto de “comunicar el riesgo” por el de “comunicar seguridad alimentaria”.